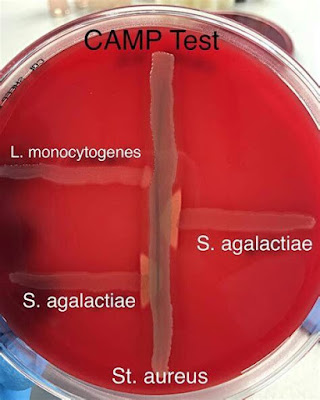

CAMP TEST
CAMP (Christie, Atkins, and Munch-Peterson) test is used for the presumptive identification of Group B Streptococcus (Streptococcus agalactiae). It is the only beta-hemolytic Streptococcus which yields a positive CAMP test. The test has been named after Christie, Atkins, and Munch-Peterson, who described it in 1944.
CAMP test is done to detect the production by group B but not other Streptococci, of a diffusible extracellular protein (CAMP factor) that acts synergistically with the β-lysin produced by Staphylococcus aureus to cause enhanced lysis of red blood cells on blood agar.
Procedure/ Method of CAMP Test
- Streak Staphylococcus aureus (ATCC 25923) down the center of a sheep blood agar plate.
- Streak the test organism across the plate perpendicular to the S. aureus streak leaving about 1 cm of space between the two streaks. (Multiple organisms can be tested on a single plate with a gap of 3-4 mm)
- Incubate the blood agar plate at 37C for overnight.
Expected Results
Positive: Enhanced hemolysis is indicated by an arrowhead- shaped zone of beta hemolysis at the juncture of two organisms.
Negative: No enhancement of hemolysis
Quality Control
Note: A similar test has been described for Listeria ivanovii, where an “arrowhead” hemolysis appears between streaks of Listeria ivanovii and Rhodococcus equi.
Reverse CAMP Test
It can be used for differentiation of Clostridium perfringens from other Clostridium species. Here, a CAMP positive Group B Streptococcus is streaked in the center of sheep blood agar, and Clostridium perfringens is streaked perpendicular to it. Following incubation at 37oC for 24-48 hours in anaerobic conditions, an “arrowhead” hemolysis is seen between the growth of Clostridium perfringens and Group B Streptococcus. This is because of alpha toxin produced by Clostridium perfringens interacts with CAMP factor and produce synergistic hemolysis.
INSTAGRAM
FACEBOOK

Hiç yorum yok:
Yorum Gönder